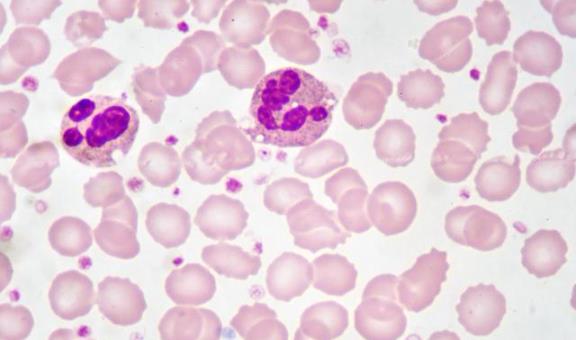

01外周血白细胞总数及分类
临床诊断和治疗感染最基本、最常用的指标,一定程度上可反应疗效和预后。
白细胞计数及中性粒细胞比例升高:急性细菌性感染。
白细胞总数升高合并淋巴细胞比例升高:急性病毒感染,如传染性单核细胞增多症,若长期持续升高,需注意与血液系统疾病,如白血病等进行鉴别。
白细胞升高合并嗜酸粒细胞比例升高:寄生虫感染、结核、变态反应、肿瘤及药物等原因。
白细胞减少:沙门菌、病毒、非典型病原体 (如支原体、衣原体、立克次体等)及某些原虫(如疟原虫、黑热病原虫 )感染。外周血白细胞影响因素极多,特异性不高。创伤、应激、药物均可引起其上升。
02红细胞沉降率(ESR)
ESR升高对诊断风湿性疾病的价值远高于感染性疾病 ,且常用于观察疾病的活动性。感染性疾病中ESR检测只对结核或植入物继发感染的诊断有一定参考价值。
03C-反应蛋白(CRP)
CRP是急性时相反应蛋白之一,是一个敏感的炎症指标,常于疾病初发的 6~8h开始升高,24~48h达到高峰,升高幅度与感染或炎症严重程度呈正相关。
细菌感染时,血清CRP可呈中等至较高程度升高,80%的患者CRP超过100mg/L,88%~94%的患者超过50mg/L。病毒感染时,CRP的水平多正常或轻度升高。
抗感染治疗过程中,动态监测 CRP水平的变化可辅助判断疗效。CRP下降至正常可作为停药的指标之一。英国胸科协会制定的指南曾推荐[1],监测CRP水平是评价社区获得性肺炎(CAP)治疗成败的有用指标。CRP≤100mg/L具有与CURB-65和肺炎严重指数(PSI)评分类似的阴性预测效果,提示无需有创呼吸支持和(或)应用血管活性药物。因此,CRP水平低的CAP患者在门诊治疗是比较安全的。
CRP的不足之处为特异性并不高,在许多非感染性疾病如外伤、手术、心肌梗死、恶性肿瘤,特别是自身免疫性疾病时也可显著升高。
04内毒素
内毒素是革兰阴性菌细胞壁中的一种特殊组分—脂多糖 ,由特异多糖、核心多糖和脂类A三部分组成。内毒素主要是在细菌死亡后从菌体中释放,也可由细菌自发地以胞吐方式释放。血浆检测内毒素通常仅需 2 小时即可完成,为临床医师指导抗生素应用及鉴别病原菌,提供了一种简便又快速的方法[2]。其不足之处为特异度较低,临床少用。
05降钙素原(PCT)
降钙素原是一种急性时相反应蛋白,其水平能反映感染性疾病的活动程度。病毒感染和非特异性炎症一般不会导致降钙素原水平升高或仅轻度升高,但细菌感染、严重休克和多器官功能衰竭综合征等都可导致降钙素原水平显著升高,且升高幅度与病情严重程度和患者预后密切相关。
因此,降钙素原检测在感染性疾病的鉴别诊断、危重患者监测及其治疗效果评估、预后判断和用药指导等方面具有很高的临床应用价值。美国FDA已批准降钙素原检测可用于辅助指导抗生素的使用。在大量临床研究的基础上,有研究者总结出了在不同降钙素原水平时的抗生素使用建议(表1)[3]。
表1 不同降钙素原水平时的抗生素使用建议/(μg/L)
图片
a)用药后每 2 ~ 3 d 检测 1 次降钙素原水平,若< 0.25 μg/L,建议停药 ;
b)用药后每 1 ~ 2 d 检测 1 次降钙素原 水平,若< 0.5 μg/L 或下降> 80%,建议停药。
06IL-6
IL-6是固有免疫系统对损伤和感染最初反应所表达的重要细胞因子,可促进肝脏产生急性阶段反应物如CRP,同时也可刺激和改变骨髓细胞,产生更多的多形核白细胞。
在炎症反应中,IL-6的升高早于其他细胞因子,也早于CRP和PCT,而且持续时间长,因此可用来辅助急性感染的早期诊断。细菌感染后IL-6水平迅速升高,可在2h达高峰,其升高水平与感染的严重程度相一致,但 IL-6用来鉴别感染与非感染的特异性不如PCT和CRP。
07肺炎链球菌尿抗原
肺炎链球菌是 CAP的最重要致病细菌 ,属难培养的“苛养菌”之一。传统的细菌培养方法阳性率低、周期长,再加上使用抗生素后阳性率更低等因素限制了其诊断价值。用体外快速免疫层析检测方法测定患者尿液肺炎链球菌抗原,可作为肺炎链球菌肺炎的辅助诊断。
尿抗原检测法操作简单、快速,且特异性较高,不受初始抗菌药物使用的影响。该方法的缺陷是感染肺炎链球菌后该抗原持续存在,3个月后浓缩尿检测仍为阳性,最长可维持 1年以上 ,既往发生过肺炎链球菌感染者可能出现假阳性,因此不适用于复发病例的检测,也较难区分现症与既往感染。
08嗜肺军团菌尿抗原
军团菌体外培养困难,阳性率极低,目前尿抗原检测法是国外诊断军团菌肺炎的一线方法[4]。该方法准确性较好 ,其诊断LP1型军团菌感染的敏感度为80%~90%,特异度>99.5%。
尿抗原检测法的缺点在于目前仅限于诊断LP1型军团菌,对于非LP1型军团菌敏感度低于50%,若仅依靠其进行诊断,容易造成漏诊。此外,部分患者抗原转阴时间过长,不能确定是新近感染还是既往感染。
09(1,3)-β-D-葡聚糖(BG)检测
BG检测又被称为G试验,葡聚糖广泛存在于真菌细胞壁中,占其干燥重量的80%~90%,其中BG占真菌壁成分的50%以上,是真菌细胞壁上的特有成分。G试验是早期诊断侵袭性真菌感染(IFI)有效的无创检测手段之一,具有较高的敏感度,阴性结果可较好排除肺部真菌感染。但其可能受到输注白蛋白、抗菌药物、血液透析、抗肿瘤药物等因素影响,会出现阳性预测值较低的问题。
10半乳甘露聚糖 (GM)试验
对于深部曲霉感染的患者,血清 GM试验增高可比影像学诊断提前7d左右出现。在重症感染患者,动态监测GM试验水平,可有助于判断真菌播散程度、治疗反应和预后。其敏感度和特异度随界值变化较大。目前,其界值国际上尚不统一。
研究结果表明[5],当采用0.5 g/L为临界值时,支气管肺泡灌洗液的GM试验对诊断的敏感度为70%~94%,特异度85%~92%。为减少假阳性及假阴性结果,我国制定的“肺真菌病诊断和治疗专家共识”中将连续2次血清GM试验阳性作为曲霉感染的辅助诊断标准。
小结
没有任何一个生物标志物是绝对敏感又绝对特异的,不能单凭某个生物标志物的改变来诊断疾病 ,只有结合 、参照患者的临床表现与其他实验室检查结果,才能做出正确的判断。